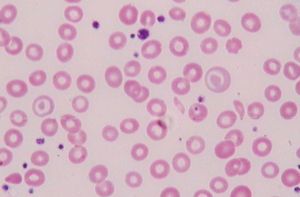

概述
缺鐵性貧血是體內用來合成血紅蛋白的儲存鐵缺乏,使血紅素合成量減少而形成的一種小細胞低色素性貧血。是一種非常常見的全球性疾病,可發生在世界各國各個民族。
據世界衛生組織調查,成年男性發病率為10%,女性為20%,孕婦40%。中國一些單位調查結果顯示,以婦女、兒童鐵缺乏和缺鐵性貧血的發生率高。
分期
1、鐵減少期:為缺鐵潛伏期,僅有儲鐵量減少。
2、鐵缺乏期:儲存鐵減少或缺乏,伴血清鐵和轉鐵蛋白飽和度下降。
3、缺鐵性貧血:儲存鐵下降或缺乏,伴血清鐵和轉鐵蛋白飽和度下降,血紅蛋白水平下降,紅細胞壓積降低。
原因
1、食物中鐵攝入不足:如營養不良、偏食、生長期嬰幼兒需要鐵劑增加。
2、吸收不良:胃酸缺乏、慢性腹瀉、胃次全切除等。
4、多次妊娠:由於胎兒生長、分娩失血、產後哺乳、需鐵量增多而未及時補充。
5、血管內溶血伴血紅蛋白尿。
6、以上幾種原因同時存在。
臨床表現
1、慢性貧血的表現:睏倦、乏力、低熱;皮膚、黏膜、指甲蒼白;氣短、心悸、胸悶、心率快;頭暈、頭痛、耳鳴、眼花、失眠;食欲不振、噁心、腹脹、便秘或腹瀉;月經不調,性功能減退;多尿、少量蛋白尿;肝脾腫大等。
2、含鐵物質缺少的表現:異食癖,口角炎,萎縮性舌炎,吞咽困難,皮膚乾燥,毛髮乾燥無光澤,易脫落,指甲脆薄,少澤,平甲或反甲。
鑑別診斷
缺鐵性貧血應與以下3種貧血相鑑別
1.地中海貧血
有家族史,血片可見大量靶形紅細胞,血紅蛋白A2增加,血清鐵蛋白及骨髓可染鐵增加。
2.慢性炎症性貧血
總鐵結合力正常或降低,血清鐵蛋白增高。
3.鐵粒幼細胞性貧血
可見環形鐵粒幼細胞,血清鐵與鐵蛋白增多,總鐵結合力降低。
檢查
1.輔助檢查
小細胞低色素性貧血:男性血紅蛋白<120g/L,女性血紅蛋白<110g/L,孕婦血紅蛋白<100g/L;MCV<80fl,MCH<26pg,MCHC<0.31;形態可有明顯低色素表現。血清鐵L,總鐵結合力>64.44umol/L,運鐵蛋白飽和度<0.15。血清鐵蛋白<14mg/L。骨髓鐵染色顯示骨髓小粒可染鐵消失,鐵粒幼紅細胞<15%。
2.實驗室檢查
(1)血象早期或輕度缺鐵可以沒有貧血或僅極輕度貧血。晚期或嚴重缺鐵有典型的小細胞低色素型貧血。紅細胞壓積和血紅蛋白濃度降低的程度通過紅細胞計數減少的程度。還可見很少的靶形、橢圓形或其他不規則形態的紅細胞。網織紅細胞計數大多正常,白細胞計數正常或輕度減低。血小板計數高低不一。
(2)骨髓象骨髓增生活躍,粒紅比例降低,紅細胞系統增生明顯活躍。中幼紅細胞比例增多,體積比一般的中幼紅細胞略小,邊緣不整齊,胞漿少,染色偏蘭,核固縮似晚幼紅細胞,表明胞漿發育落後於核,粒系細胞和巨核細胞數量和形態均正常。
(3)骨髓鐵染色用普魯土蘭染色可見骨髓含鐵血黃素陰性(正常為+~++),鐵粒幼細胞陰性或減少(正常為20%~90%)。
(4)血清鐵蛋白鐵蛋白是體內儲存鐵的一種形式,血清鐵蛋白也可以起到運鐵的作用,通常1ug/L代表體內有儲存鐵8mg,故血清鐵蛋白的測定是估計骨髓鐵貯存狀態的一種敏感的方法,血清鐵蛋白正常值為100±60ng/ml),缺鐵性貧血時小於15ug/L(15ng/ml)。
(5)血清鐵缺鐵性貧血時血清鐵常低於10.74umol/L(60ug/100ml),總鐵結合力增高,高於64.44umol/L(360ug/100ml),血清鐵飽和度減少,低於15%.
(6)紅細胞游離原卟啉(FEP)正常為0.29~0.65umol/L(16~36ug/dl),缺鐵貧血時增高。此外,其他血紅素合成障礙的疾病,如鉛中毒和鐵粒幼細胞性貧血時,FEP亦增加,故FEP可做為初篩試驗。
治療
1、積極尋找病因。對因治療。
2、飲食治療:多吃含鐵量高的食物。含鐵量最高的食物有:海帶、髮菜、紫菜、木耳、香菇、動物肝及血,其次為豆、肉、穀物、乳類、蔬菜,水果含鐵量低,且不易吸收(<8%)。
3、鐵劑治療:
(1)口服鐵劑,是治療本病的主要方法。
(2)注射鐵劑,要慎用,掌握好適應症,在醫生的指導下可使用右鏇糖酐鐵,山梨醇鐵溶液等。
若治療欠佳,可能是由於繼續出血、原發病、感染或惡性病仍存在,鐵攝入不足,或是罕見情況下由於口服鐵吸收不良。當血紅蛋白接近正常時,恢復速度逐漸減慢,補鐵治療應繼續進行大於等於6個月,以補足組織中的鐵貯備。
預防
缺鐵性貧血 缺鐵性貧血大多是可以預防的,在易發生這類貧血的人群中應重視開展衛生宣教和採取預防措施,例如:
(1)改進嬰兒的哺乳方法,及時增加適當的輔助食品;
(2)積極貫徹計畫生育、防止生育過多過密;
(3)在妊娠後期和哺乳期間可每日口服硫酸亞鐵0.2或0.3g;
(4)在鉤蟲病流行地區進行大規模的寄生蟲病防治工作;
(5)及時處理慢性出血灶。
相關研究
腎臟病患者和孕婦患病率高
據復旦大學公共衛生學院2012年10月31日在京發布的《中國缺鐵性貧血疾病負擔和診療現狀研究報告》顯示,腎臟病患者和孕婦的缺鐵性貧血患病率較高。
研究表明,慢性腎病患者和懷孕婦女是缺鐵性貧血的高危人群,特別是正在接受血液透析治療的慢性腎病患者更容易患缺鐵性貧血,而婦產科醫師對缺鐵性貧血診療指南的了解和套用有待加強
據北京醫院腎臟內科主任醫師吳華介紹,缺鐵性貧血會嚴重降低病人的生活質量,增加住院甚至死亡的風險,同時也增加了患者的醫療負擔。數據顯示,合併缺鐵性貧血的慢性病患者的醫療費會增加30%至40%。
在治療方式上,研究發現靜脈注射鐵劑起效快、副作用小,整體療效優於傳統口服鐵劑,但現有的診療指南有待完善。
貧血可能是腸癌信號
2013年1月,英國《結腸直腸病》雜誌刊登新研究發現,不少患者出現的不明原因的缺鐵性貧血可能是結腸直腸癌的早期症狀。英國達勒姆大學教授S·達梅里博士及其同事對至少62.8萬名40歲以上的患者進行了研究。參試者接受了缺鐵性貧血篩查,結果發現1/3缺鐵性貧血患者後來都患上了結腸癌。研究人員表示,結直腸癌早期症狀不明顯,通常要發展到一定程度才會有症狀。比如,身體不明原因消瘦、排便習慣改變、大便性狀改變、腹痛或腹部不適、腹部腫塊、腸梗阻等。另外,不明原因貧血也是早期結直腸癌的表現之一。應引起醫生和患者的高度警惕。